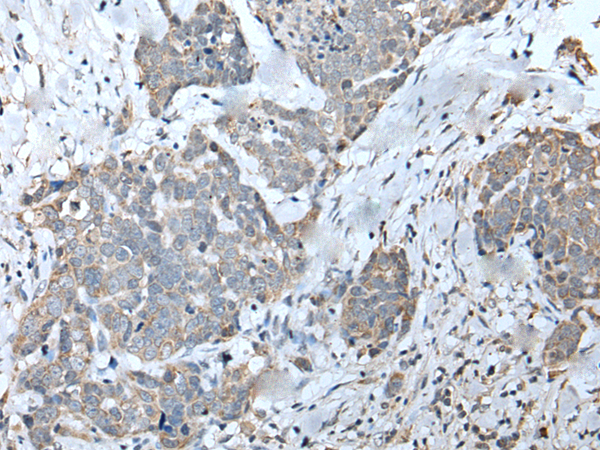
一抗

中文名稱:兔抗EFNB3多克隆抗體
|
Background: |
EFNB3, a member of the ephrin gene family, is important in brain development as well as in its maintenance. Moreover, since levels of EFNB3 expression were particularly high in several forebrain subregions compared to other brain subregions, it may play a pivotal role in forebrain function. The EPH and EPH-related receptors comprise the largest subfamily of receptor protein-tyrosine kinases and have been implicated in mediating developmental events, particularly in the nervous system. EPH Receptors typically have a single kinase domain and an extracellular region containing a Cys-rich domain and 2 fibronectin type III repeats. The ephrin ligands and receptors have been named by the Eph Nomenclature Committee (1997). Based on their structures and sequence relationships, ephrins are divided into the ephrin-A (EFNA) class, which are anchored to the membrane by a glycosylphosphatidylinositol linkage, and the ephrin-B (EFNB) class, which are transmembrane proteins. The Eph family of receptors are similarly divided into 2 groups based on the similarity of their extracellular domain sequences and their affinities for binding ephrin-A and ephrin-B ligands. |
|
Applications: |
ELISA, WB, IHC |
|
Name of antibody: |
EFNB3 |
|
Immunogen: |
Synthetic peptide of human EFNB3 |
|
Full name: |
ephrin-B3 |
|
Synonyms: |
EFL6; EPLG8; LERK8 |
|
SwissProt: |
Q15768 |
|
ELISA Recommended dilution: |
5000-10000 |
|
IHC positive control: |
Human cervical cancer |
|
IHC Recommend dilution: |
20-100 |
|
WB Predicted band size: |
36 kDa |
|
WB Positive control: |
K562,SKOV3 and NIH/3T3 cell lysates |
|
WB Recommended dilution: |
200-1000 |


 購物車
購物車 幫助
幫助
 021-54845833/15800441009
021-54845833/15800441009